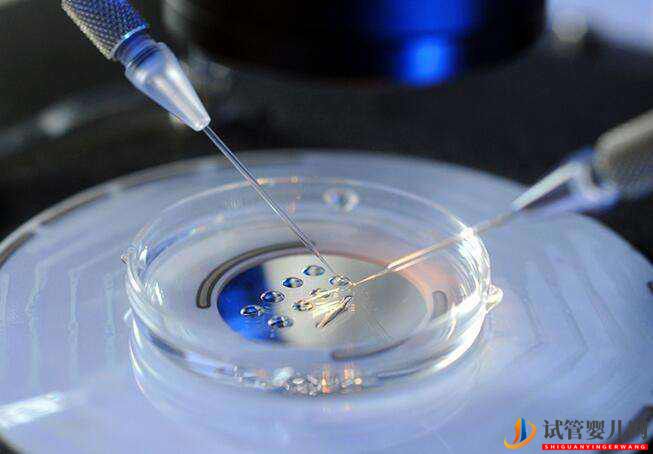
女人做試管嬰兒取卵痛嗎女人做了試管人就廢了嗎(圖1)

?
91精品久久久久久久久久不卡|
av一本久道久久综合久久鬼色|
日韩少妇中文字幕|
免费黄色网页|
午夜精品久久久久久久久久|
亚洲欧美视频在线播放|
天天综合91|
欧美国产日本高清在线|
天天舔天天干天天操|
精品无码三级在线观看视频|
国产精品日韩三级|
国产精品一区在线看|
正在播放一区二区|
国产视频91在线|
91精品观看|
国内一区二区三区在线视频|
免费网站www在线观看|
精品成人在线视频|
欧美a在线播放|
免费一区二区|
999国内精品视频在线|
先锋av在线资源|
亚洲综合丁香婷婷六月香|
中文精品在线观看|
欧美三级电影在线|
成人福利视频网|
午夜高潮免费视频|
亚洲免费资源在线播放|
7788色淫网站小说|
国产劲爆久久|
国产欧美在线观看|
深夜福利av你懂的|
欧美午夜激情视频|
看片网站在线观看|
欧美一区高清|
亚洲电影网站|
91在线网址|
亚洲精品久久久久中文字幕二区|
日本一区二区三区久久|
青青草成人在线观看|
少妇人妻无码专区视频|
第四色日韩影片|
久久久成人av|
欧美日韩综合高清一区二区|
欧美激情在线免费观看|
午夜久久久久久久|
免费成人高清在线视频theav|
99电影网电视剧在线观看|
狠狠干五月天|
欧美日韩国产123区|
综合网在线观看|
视频一区二区中文字幕|
a级黄色一级片|
美女的胸无遮挡在线观看
|
快射av在线播放一区|
日韩精品免费在线|
а√天堂资源在线|
99精品桃花视频在线观看|
日本美女久久久|
国产精品99久久免费观看|
亚洲xxxxx电影|
男人在线视频资源|
欧美一区二区三区视频免费播放|
伊人成人在线观看|
国产成人免费视频|
无码人妻丰满熟妇区毛片蜜桃精品
|
午夜伦理在线视频|
欧美大码xxxx|
91视频地址|
午夜精品视频一区|
亚洲欧美在线观看视频|
日韩成人免费电影|
三上悠亚av一区二区三区|
国产精品xnxxcom|
91久久久久久久久久久久久|
最近2018中文字幕免费在线视频|
日韩亚洲欧美一区二区三区|
国产aⅴ一区二区三区|
99视频一区二区三区|
99久久免费看精品国产一区
|
国产不卡在线观看视频|
狠狠色综合网|
青青草精品视频在线|
成人自拍视频网|
国产精品香蕉在线观看|
宅男午夜在线|
亚洲精品久久久久国产|
天堂网中文在线|
亚洲男帅同性gay1069|
久久免费公开视频|
日韩国产一区二|
亚洲第一色av|
亚洲宅男网av|
亚洲午夜在线观看|
国产盗摄——sm在线视频|
日本电影亚洲天堂|
日本夜爽爽一二区|
亚洲精品97久久|
四虎影院成人在线观看|
亚洲黄色av一区|
a v视频在线观看|
国产乱码精品一区二区三区五月婷
|
天堂av一区|
久久精品国产第一区二区三区最新章节|
香港伦理在线|
精品视频9999|
一插菊花综合|
欧美精品一区二区三区四区|
日本男人天堂网|
亚洲成人自拍一区|
免费一级a毛片|
99re6这里只有精品视频在线观看|
亚洲a v网站|
亚洲综合日韩|
www.亚洲自拍|
性欧美欧美巨大69|
日日鲁鲁鲁夜夜爽爽狠狠视频97|
www.成人网|
亚洲欧美日韩国产成人综合一二三区|
亚洲天堂手机|
91久久久一线二线三线品牌|
日本在线免费播放|
欧美一区二区三区图|
黄页视频在线观看|
日韩在线小视频|
在线观看成人影院|
亚洲精品一区中文字幕乱码|
91短视频推广|
欧美成人bangbros|
九色porny丨精品自拍视频|
日本久久一区二区|
嫩草影院一区二区|
亚洲成a人片在线观看中文|
在线播放一级片|
国产精品久久久久久妇女6080|
日韩三级一区二区三区|
av午夜一区麻豆|
国产av无码专区亚洲av毛网站|
国产米奇在线777精品观看|
中文字幕xxx|
热久久一区二区|
国产又黄又粗又猛又爽的视频|
99热精品在线|
手机在线免费毛片|
国内综合精品午夜久久资源|
视频免费1区二区三区|
欧美午夜不卡|
五月天开心婷婷|
欧美婷婷在线|
人妻少妇偷人精品久久久任期|
欧美成人久久|
√天堂资源在线|
在线观看不卡|
成人在线观看一区二区|
日韩视频二区|
逼特逼视频在线观看|
国产精品日韩|
在线免费观看a级片|
日韩电影在线观看电影|
中日韩精品一区二区三区|
免费人成在线不卡|
成人在线手机视频|
国产乱码精品一区二区三区忘忧草|
麻豆精品国产免费|
成人激情免费电影网址|
国产精品a成v人在线播放|
26uuu另类欧美|
无码人妻一区二区三区免费|
国产精品福利影院|
国产毛片毛片毛片毛片|
精品久久久久久久久久久|
男女作爱免费网站|
337p亚洲精品色噜噜噜|
天堂视频在线免费观看|
亚洲人成电影在线播放|
激情av网站|
久久全球大尺度高清视频|
成人在线高清视频|
国产精品一区二区久久久|
xxx在线免费观看|
久久香蕉综合色|
日韩一二三区|
蜜桃传媒一区二区三区|
**女人18毛片一区二区|
亚洲精品一二三四|
日本亚洲视频在线|
欧美做爰爽爽爽爽爽爽|
久久久.com|
97精品人妻一区二区三区在线
|
午夜成人影视|
国产精品美女视频网站|
91在线超碰|
热舞福利精品大尺度视频|
日韩成人视屏|
欧美视频第一区|
国产一区观看|
成都免费高清电影|
99久久久精品|
国产日韩在线免费观看|
精品成人乱色一区二区|
欧美成人3dxxxx|
亚洲精品一区二区三区不|
日本韩国在线视频|
日韩免费精品视频|
涩涩视频在线免费看|
无遮挡亚洲一区|
亚州av日韩av|
992kp免费看片|
蜜乳av一区二区三区|
妺妺窝人体色www聚色窝仙踪|
国产精品美女久久久久高潮|
亚洲精品无码专区|
欧美mv日韩mv国产|
少妇高潮露脸国语对白|
国产精品第一视频|
电影一区二区三区|
久久观看最新视频|
91精品久久久久久久蜜月|
亚洲精品乱码久久|
成人毛片在线观看|
国产老妇伦国产熟女老妇视频|
欧美日韩在线亚洲一区蜜芽|
黄色激情视频网址|
久久久久国产精品免费|
国产网红女主播精品视频|
日韩精品欧美一区二区三区|
欧美老女人另类|
jjzz黄色片|
成人免费视频视频在线观看免费|
最好看的日本字幕mv视频大全|
欧美在线播放高清精品|
h网站在线看|
欧美专区国产专区|
天天综合网站|
国产午夜福利在线播放|
亚洲欧美日本日韩|
精品少妇久久久|
无码av免费一区二区三区试看
|
成人xxxxx色|
超碰成人在线免费|
99中文字幕在线|
丰满少妇久久久久久久|
97成人在线观看|
日韩你懂的在线播放|
轻轻色免费在线视频|
亚洲一区二区少妇|
91综合精品国产丝袜长腿久久|
亚洲欧美日韩一二三区|
成人免费毛片片v|
av中文字幕第一页|
亚洲精品v天堂中文字幕|
青青草视频在线观看|
久久www免费人成精品|
精品国产视频|
精品人妻无码一区二区三区
|
午夜国产福利视频|
一区二区三区在线免费视频|
国产精品亚洲第五区在线
|
在线精品视频视频中文字幕|
久久综合之合合综合久久|
亚洲精品一区二区三区蜜桃久|
仙踪林久久久久久久999|
国内毛片毛片毛片毛片毛片|
一区二区视频免费在线观看|
影音先锋2020资源|
69av在线视频|
日韩一级视频|
下面一进一出好爽视频|
99久久99久久精品免费看蜜桃|
婷婷丁香花五月天|
这里只有精品视频|
国产乱妇乱子在线播视频播放网站|
国产乱子伦精品视频|
日韩高清在线不卡|
中文字幕欧美人妻精品一区蜜臀|
欧美成人综合网站|
国产youjizz在线|
亚洲成人网上|
精品999日本|
久久久久久少妇|
日韩欧美亚洲一区二区|
国产九色在线|
国产美女视频免费|
久久一综合视频|
91禁在线观看|
日韩av在线一区二区|
国产黄色在线免费观看|
国产一区二区片|
奇米一区二区三区|
国产成人三级在线播放|
中文字幕精品网|
亚洲第一av|
手机看片一级片|
久久久久青草大香线综合精品|
欧美www在线观看|
欧美综合在线观看|
gogo人体一区|
国产探花视频在线播放|
亚洲成人免费在线|
美女激情网站|
欧美大香线蕉线伊人久久|
激情欧美亚洲|
天天爱天天做天天爽|
亚洲精品黄网在线观看|
国产啊啊啊视频在线观看|
欧美xxxxx在线视频|
成人av在线一区二区三区|
欧美性猛交xxxx乱大交丰满|
91成人在线视频|
1204国产成人精品视频|
免费看黄色三级|
一本色道久久加勒比精品|
亚洲最新合集|
欧美日韩视频免费在线观看|
老司机免费视频一区二区三区|
国精产品一品二品国精品69xx|
久久手机免费视频|
电影中文字幕一区二区|
久久人人爽人人爽人人片|
亚洲444eee在线观看|
资源视频在线播放免费|
自拍视频一区二区三区|
狠狠色伊人亚洲综合成人|
1区2区视频|
日韩免费观看在线观看|
加勒比久久综合|
日本在线视频免费|
日韩电影大片中文字幕|
小视频免费在线观看|
亚洲精品乱码久久久久久9色|
亚洲你懂的在线视频|
狠狠干夜夜操|
中文字幕成人一区|
国产在线视频不卡二|
一日本道久久久精品国产|
国产精品久久一|
91亚洲国产成人久久精品|
无码人妻精品一区二区三区不卡
|
亚洲激情视频小说|
在线日韩一区二区|
av资源种子在线观看|
亚洲国产精品久久久久爰色欲|
久久伊人中文字幕|
好爽好深好紧好大|
久久久久久久有限公司|
日韩成人伦理电影在线观看|
男女下面一进一出无遮挡|
国产精品偷伦一区二区|
欧美1区2区3区|
国产精品久久777777换脸|
欧美激情一区二区三级高清视频|
韩国精品福利一区二区三区|
久久精品国产av一区二区三区|
亚洲护士老师的毛茸茸最新章节
|
性久久久久久久久久久久久久|
亚洲午夜成aⅴ人片|
瑟瑟在线观看|
亚洲中文字幕无码中文字|
国产精品免费人成网站|
精品剧情v国产在线观看|
日本免费黄色小视频|
99久久精品免费看国产免费软件|
黄色免费视频在线观看|
日韩精品不卡|
国产成人aaa|
岛国在线免费|
日本黄网免费一区二区精品|
国产麻豆精品95视频|
豆国产97在线|亚洲|
九色91国产|
精品亚洲成a人在线观看|
小小的日本在线观看免费色网|
精品国产一区二区三区麻豆免费观看完整版
|
欧美日韩一区二区三区免费|
精品午夜久久福利影院|
一级黄色免费|
欧美日韩高清免费|
国产精品中文字幕欧美|
免费做暖暖免费观看日本|
日韩高清dvd|
成人sese在线|
www.亚洲|
岛国大片在线播放|
国产精品蜜臀在线观看|
在线国产福利网站|
亚洲 中文字幕 日韩 无码|
亚洲va韩国va欧美va|
国产激情小视频在线|
久久久久亚洲无码|
91精品国产综合久久小美女|
日韩精品一区二区三区|
日本 欧美 国产|
亚洲欧美制服中文字幕|
精品欠久久久中文字幕加勒比|
天堂网视频在线|
国产+成+人+亚洲欧洲|
亚洲精品a级片|
男人猛进猛出女人屁股视频|
97人人模人人爽人人少妇|
久久av中文字幕片|